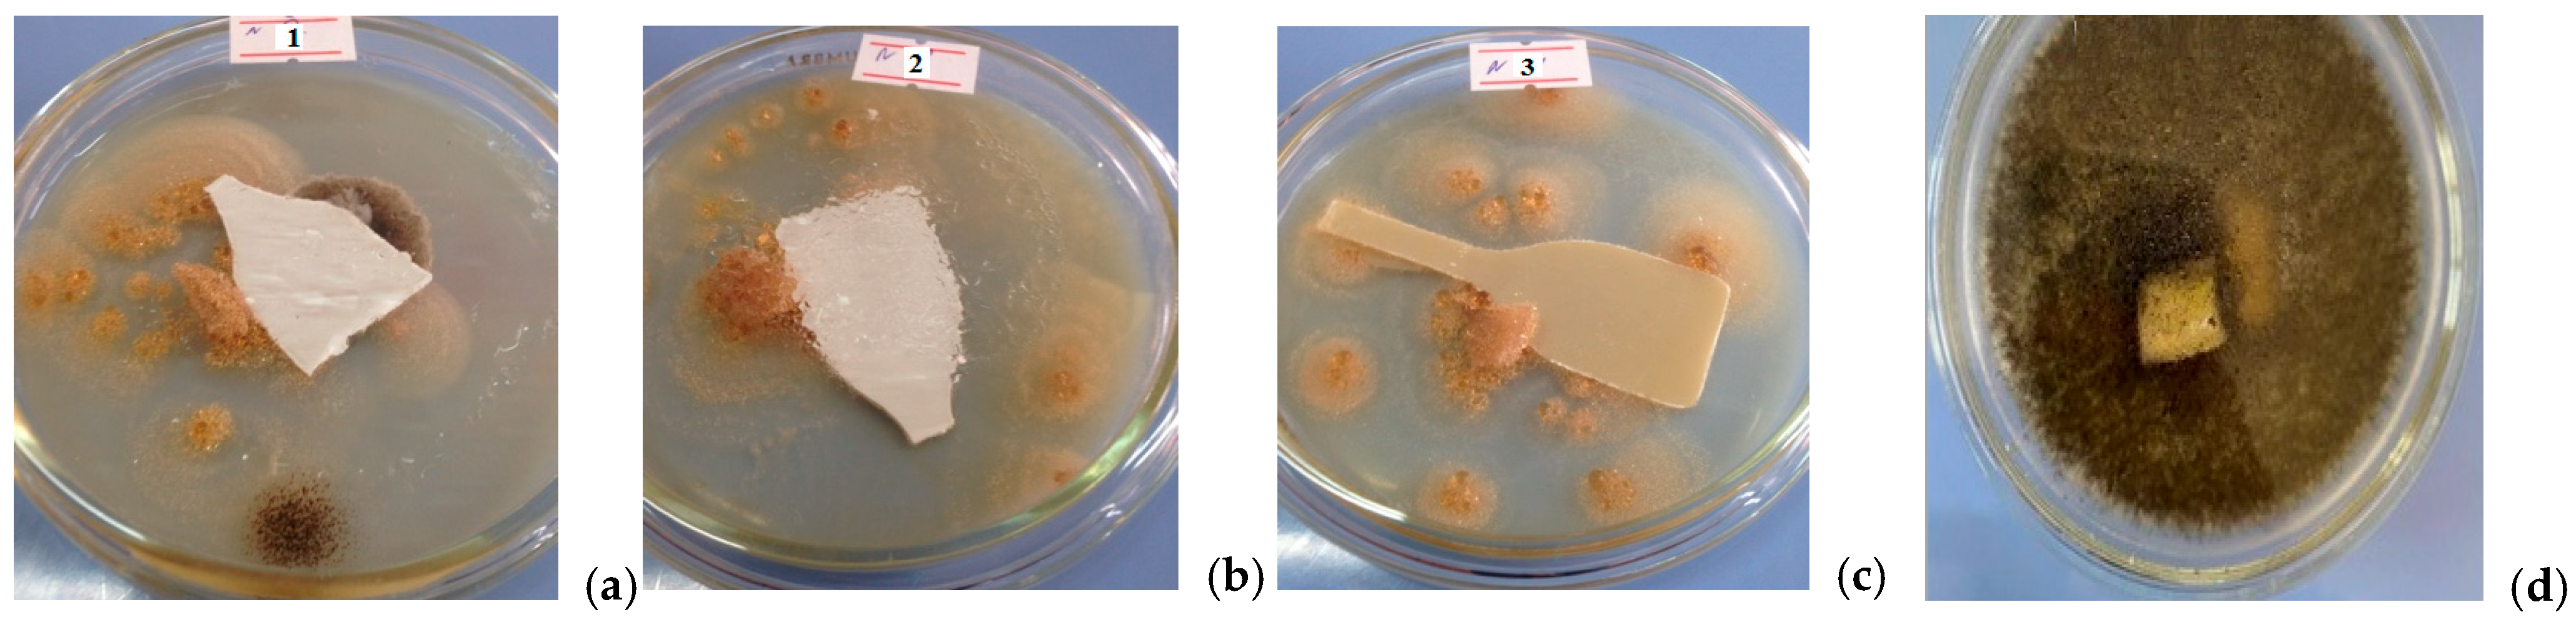
Molecules 31 00190 g003

Abstract
This work presents the results of the synthesis and investigation of new antibacterial composite materials based on acrylonitrile–butadiene–styrene (ABS) copolymer and o-, m-, p-carboxyphenylmaleimides (CPhMI). The composites were obtained by thermal mixing with varying contents of different CPhMI isomers in the polymer matrix. The structural and thermal characteristics of the synthesized materials were investigated using IR and UV spectroscopy, as well as thermogravimetric (TGA) and differential thermal analysis (DTA). The results indicate that the o-isomer imparts the highest thermal stability, while the p-isomer shows slightly lower stability. In terms of processability, the m-isomer exhibits the highest melt flow, the p-isomer an intermediate level, and the o-isomer the lowest. The antibacterial activity of the composites was evaluated by the agar diffusion method against Gram-positive (Staphylococcus aureus) and Gram-negative (Escherichia coli) microorganisms. All synthesized samples exhibited strong antibacterial activity against S. aureus and E. coli at a concentration of 0.5 wt%, confirming their potential for application in medical devices, as well as in sanitary polymer coatings and packaging.
1. Introduction
Demand for antimicrobial materials is growing rapidly, especially in the healthcare, food safety, and consumer goods manufacturing sectors, where microbial contamination can harm human health and reduce product quality [1,2,3,4,5]. The housings, cases, and polymer coatings of medical devices such as blood pressure monitors, thermometers, inhalers, nebulizers, and others, when repeatedly used in outpatient clinics, eventually become a source of infection.
Acrylonitrile butadiene styrene (ABS) is a versatile thermoplastic polymer widely used in mechanical engineering, aviation, pharmaceuticals, medicine [6], and household appliances [7] due to its excellent mechanical strength, impact resistance, and ease of processing. However, in environments where hygiene is crucial, such as medical facilities, food packaging, and household appliances, conventional ABS is not resistant to microbial contamination. To overcome this limitation, researchers have developed composite materials (CM) based on ABS with the addition of antibacterial agents that can effectively suppress the growth of pathogenic microorganisms. Furthermore, these advanced composites not only retain the desirable structural and technological properties of ABS, but also provide increased safety, durability, and functionality, making them highly valuable for applications that require both the necessary mechanical characteristics and antimicrobial protection [8,9,10]. Recently, efforts have focused on improving the properties of ABS using high-molecular-weight antimicrobial additives. Antibacterial composites made from ABS plastic can be used in the manufacture of medical equipment, protective devices, and on surfaces in hospitals to reduce the risk of infection [11,12,13].
Polymer materials are often subject to biocorrosion. In this case, they are damaged by microfungi; bacteria absorb additives in plastic products, reducing their quality and service life, thereby turning them into a source of infection. To prevent this, natural and synthetic biologically active additives (BAA) are introduced into polymer composite materials during the extrusion process. Currently, there are many known biocidal additives. However, strict requirements for polymer additives, such as relatively high heat resistance, toxicity, miscibility with other components, and many others, limit their application [14,15,16,17,18,19,20].
Commonly used polymers are typically employed as a matrix for obtaining bactericidal polymer compositions [21]. Silver metal powder and silver salts are widely used as antimicrobial additives to polyolefins, polystyrene, styrene copolymers, polyamides, and their mixtures with polyethylene and ABS, despite their high cost [22,23].
A common drawback of most analogs and composite materials is the gradual loss of their bactericidal and fungicidal properties as a result of surface leaching of the biocidal ingredient [24,25,26,27].
The aim of the study was to develop antibacterial composite materials that possess favorable polymer properties for use in medical devices.
The objective of the research is to obtain new antibacterial composite materials based on ABS with a broad spectrum of antibacterial activity, using compounds containing imide and carboxyl groups in the macromolecule, in particular CPhMIs as biologically active additives [28].
2. Results
2.1. Identification of Compositions of o-, m-, p-Carboxyphenylmaleimide/ABS
Based on the results of IR spectroscopy, the composition of the composite materials are shown in Figure 1.
Figure 1.
IR spectrum of the composition o- (a), m- (b), p-carboxyphenylmaleimides (c)/ABS.
The following absorption bands were observed in the IR spectrum: deformation vibrations of the C–H bonds of the CH2 and CH3 groups at 1451 cm−1, valence vibrations of the C–H bonds at 2851 and 2918 cm−1, deformation vibrations of the C–H bond of the m-substituted benzene ring at 758 cm−1; valence vibrations of the C–C bond of the benzene ring at 1602 cm−1, the C–O bond at 1028 and 1157 cm−1, and the C=O bond at 1720 cm−1 [29,30,31]. Pure ABS plastic has a characteristic absorption band at 698 cm−1 for the –CH2 vibration, while the band at 2235 cm−1 was due to the -R-C≡N group.
Based on the results of UV spectroscopy, the composition of the composite materials are shown in Figure 2.
Figure 2.
UV spectrum of the composition o- (a), m- (b), p-carboxyphenylmaleimides (c)/ABS.
To study the electronic transitions in the synthesized o-, m-, and p-isomers of CPhMI, UV spectra were recorded. The spectra of all samples exhibit characteristic absorption bands due to π→π* and n→π* transitions in aromatic and imide conjugated systems.
For the o-isomer, intense absorption bands appear at 228–235 nm and 242–250 nm, corresponding to π→π* transitions in the butadiene and phenyl moieties. In the 258–270 nm region, a π→π transition of the maleimide unit is observed, along with the onset of an n→π* transition of the C=O bond. Bands at 275–290 nm are associated with the n→π* transition of the imide carbonyl, with only a minor influence from the nitrile group. In the 295–305 nm range, slight band shifts may occur due to intramolecular hydrogen bonding. In the range of 300–320 nm, a hybrid π→π*/n→π* transition of the conjugated aromatic-imide system is observed, followed by a sharp decrease in intensity (320–340 nm).
The m-isomer is characterized by absorption bands at 225–232 nm (π→π* transitions of butadiene and styrene fragments) and 240–248 nm (phenyl system). In the 250–265 nm region, a π→π* transition of the maleimide group is observed; due to weaker resonance interaction, the peaks are shifted to the short-wave region. At 275–285 nm, an n→π* transition of the imide fragment is recorded.
The p-isomer is characterized by bands at 230 nm (π→π* transition of butadiene and phenyl fragments), 245 nm (π→π* transition of the phenyl link), and a narrow peak at about 255 nm associated with an aromatic or maleimide π→π* transition. In the 280 nm region, an n→π* transition of the maleimide carbonyl group and a weak influence of the nitrile group are recorded. The band at 295–300 nm is due to the hybrid transition of the conjugated aromatic-imide system, followed by a sharp decrease in intensity (320–340 nm).
The o- and m-isomers are characterized by a stable absorption zone of 270–285 nm, corresponding to the n→π* (C=O) transition and the influence of the nitrile group. For the p-isomer, the main stable region is 280–295 nm, which indicates more pronounced conjugation and interaction between the aromatic and imide systems.
The general region of intense absorption for all isomers is 200–320 nm, typical for polymers with conjugated aromatic-imide chains.
2.2. Physical and Mechanical Parameters of CM Based on o-, m-, p-CPhMI/ABS
Changes in the physical and mechanical properties of ABS-based composite materials during extrusion with the addition of biologically active additives (BAA) based on 0.50 ÷ 3.0% carboxyphenylmaleimides are shown in Table 1.
Table 1.
Physico-mechanical parameters of the antibacterial CM based on o-, m-, p-carboxyphenylmaleimides/ABS.
As can be seen from Table 1, the physical and mechanical properties of composite materials containing 0.50% BAA (carboxyphenylmaleimides) change only slightly compared to the original ABS, which is likely due to the organic nature and low amount of bactericidal additives. All physico-mechanical measurements were carried out in four independent replicates (n = 4), and the reported values correspond to the mean of these measurements.
2.3. Antibacterial Evaluation
The antimicrobial activity of the synthesized carboxyphenylmaleimide monomers was evaluated using the disk-diffusion method. The compounds showed significant effects against isolated microbial cultures in concentrated form, while their aqueous solutions exhibited only weak activity, with the strongest inhibition observed against Candida albicans. The resistance of ABS-based composites containing these additives was also assessed against microfungi (Aspergillus niger, A. ochraceus, Penicillium cyclopium, Cladosporium herbarum, Fusarium moniliforme, and F. oxysporum) over a one month period in a nutrient medium. Except for unmodified ABS, no fungal colonization or surface degradation was observed, based on visual inspection (Figure 3).
Figure 3.
Antibacterial activity of the composition o- (a), m- (b), p-carboxyphenylmaleimides (c)/ABS and neat ABS (d).
In summary, while the antimicrobial activity is primarily attributable to the pure carboxyphenylmaleimide compounds, ABS composites containing small amounts of these additives effectively resist fungal growth in the solid state, and their incorporation has minimal impact on the physical and mechanical properties of the materials, supporting their potential application in practical settings.
2.4. In Silico Studies
Computer studies were conducted using recognized online prediction platforms to obtain preliminary information about the biological activity and safety profile of the initial low-molecular-weight compound. Potential antimicrobial activity was assessed using the PASS Online server (Way2Drug, https://www.way2drug.com, accessed on 18 November 2025), which uses structure-activity relationship models to predict possible biological effects based on chemical structure similarity. The predictions provided qualitative estimates of the likelihood of interaction with various types of microorganisms and were used for comparative analysis of the compound’s isomers. Toxicological properties were further evaluated using the ProTox-3.0 platform (https://tox.charite.de/protox3, accessed on 18 November 2025), which predicts general toxicity endpoints based on molecular structure and machine learning models. In addition, carcinogenicity was assessed using the CarcinoPred-EL (http://112.126.70.33/toxicity/CarcinoPred-EL/result/?id=W9nk0Y4K3oTGql8OoXzc, accessed on 18 November 2025) web server, which uses ensemble learning algorithms, including random forest, support vector machine, and XGBoost models, in combination with several molecular descriptors (CDK, CDKExt, CDKGraph, KR, KRC, MACCS, and PubChem fingerprints). The results of the calculations were interpreted qualitatively and used as supplementary information to complement the experimental results, rather than as definitive evidence of biological efficacy or toxicity.
The in silico toxicity assessment performed using the ProTox-3.0 platform [32] predicted an LD50 value of 710 mg/kg for oral administration for the test compound, which corresponds to toxicity class 4 according to the Globally Harmonized System. This classification indicates a moderate level of acute toxicity. The prediction was obtained with an average structural similarity of 68.83% to compounds in the reference dataset and an overall prediction accuracy of 68.07%, indicating reasonable model reliability.
These results indicate that this compound is unlikely to pose a significant risk of carcinogenicity or environmental toxicity, confirming its potential suitability for use in polymer or biomedical composite materials.
2.5. Study of Dynamic and Kinematic Viscosity of the Composition
A comparative study of the dynamic and kinematic viscosity of composite materials based on o-, m-, p-CPhMI/ABS was conducted over a range of temperatures following the methodology described in [33,34].
A comparative study of the dynamic and kinematic viscosity of composite materials based on o-, m-, and p-CPhMI/ABS was conducted over a temperature range of 15–45 °C (Table 2). All measurements were performed in triplicate.
Table 2.
Dynamic (a) and kinematic (b) viscosity of the CM based on o- (a), m- (b), p-carboxyphenylmaleimides (c)/ABS at different temperatures.
As the temperature increases, all the samples studied exhibit a consistent decrease in dynamic viscosity, which is associated with increased macromolecular mobility and the weakening of intermolecular interactions in the polymer matrix. The composition of p-CPhMI/ABS occupies an intermediate position in terms of viscosity, while o-CPhMI/ABS exhibits the highest values, which indicates, in this case, a denser packing of macromolecules and the presence of additional intermolecular bonds.
A similar trend can be observed in the graphs showing the dependence of kinematic viscosity on temperature (Figure 4): when heated, the viscosity of all samples of the composition decreases, but the relative ratio between the isomers added to the composition remains unchanged. The most fluid samples are those containing the m-isomer, which has the lowest steric hindrance and the weakest intramolecular interactions. Samples obtained with the p-isomer demonstrate an average viscosity value among the compositions obtained, which may be due to a more symmetrical structure and a moderate degree of interaction between the aromatic and imide fragments. While compositions obtained with the o-isomer are characterized by the highest viscosity, which is explained by the possible formation of intramolecular hydrogen bonds between the carboxyl and imide groups, as well as the restriction of chain mobility due to spatial factors.
Figure 4.
Dynamic (a) and kinematic (b) viscosity of the composition o-, m- and p-carboxyphenylmaleimides/ABS at different temperatures.
Thus, the data obtained indicate that the rheological behavior of the composites under study directly depends on the position of the substituents in the phenyl ring of the carboxyphenylmaleimide fragment. The isomeric structure determines the degree of conjugation and intermolecular interactions during the formation of the composition and, as a result, the viscosity characteristics of the resulting composite materials.
2.6. Study of Thermal Properties of the Composition
The results of the Differential Thermal Analysis (DTA) and Thermogravimetric Analysis (TGA) of the obtained composite materials based on o-, m-, p-CPhMI/ABS have also been determined [35,36].
The thermal behavior of the material was investigated using thermogravimetric analysis (TGA), derivative thermogravimetry (DTG), and differential thermal analysis (DTA) (Figure 5). The TGA curve (pink) shows the change in sample mass as a function of temperature, providing information on thermal stability and decomposition stages; temperature intervals with insignificant mass loss indicate thermally stable regions, while sharp decreases correspond to decomposition processes. The DTG curve (green), representing the first derivative of the TG signal, reflects the rate of mass loss and allows the stages of degradation to be precisely determined, with a pronounced minimum observed in the range of approximately 422–451 °C corresponding to the main decomposition event. The DTA curve (blue) records the thermal effects associated with endothermic and exothermic processes; shifts in the baseline on this curve are explained by the glass transition temperature (Tg), which is not accompanied by mass loss, as confirmed by the constant TG profile in this region. Distinct DTA peaks indicate thermal or chemical transformations occurring during heating. The shaded areas under the DTA peaks represent the enthalpy change (ΔH) of the corresponding thermal events and are expressed as integrated areas (μV·s).

Figure 5.
Thermogravimetric (TG) and Differential Thermal Analysis (DTA) of o- (a), m- (b), and p- (c) carboxyphenylmaleimides/ABS Compositions.
The activation energy was calculated using the double-logarithm method presented in the work (Table 3). The activation energy of thermal degradation was determined using the double logarithmic method based on thermogravimetric (TG) analysis [37]. The onset temperature of degradation (Tn) was first identified from the TG curve. Subsequently, the mass loss of the sample (ΔG) was recorded at 10 °C temperature intervals above Tn.
Table 3.
Mass loss and activation energy during thermodestruction of CM based on ABS and o-, m-, p-carboxyphenylmaleimides.
For each temperature interval i, the ratio of successive mass losses was calculated as:
The obtained ratios were subjected to double logarithmic transformation according to:
The activation energy of degradation (Ea) was calculated using the equation:
The thermal stability of ABS composites with o-, m-, and p-carboxyphenylmaleimides showed that o- and p-isomers significantly increase thermal stability and glass transition temperature compared to pure ABS.
Although pure ABS was not investigated experimentally in this study, comparison with well-documented literature data indicates that the incorporation of o- and p-carboxyphenylmaleimide fragments into the ABS matrix results in an increase in the glass transition temperature and a shift in the main thermal decomposition stage toward higher temperatures. Thermal analysis of the ABS composites modified with o-, m-, and p-carboxyphenylmaleimides demonstrates that the o- and p-isomers provide a pronounced improvement in thermal stability and glass transition temperature relative to typical ABS systems, whereas the m-isomer exhibits a weaker stabilizing effect. These findings indicate an overall enhancement of the thermal stability of ABS composites upon incorporation of structurally favorable carboxyphenylmaleimide units.
The composite with o-CPhMI demonstrated the highest thermal stability (Tg ≈ 107 °C, decomposition peak ≈ 421 °C), while p-CPhMI improved carbon residue formation and polymer matrix rigidity, and the composition obtained with the m-isomer is characterized by a reduced Tg (≈80 °C) and minimal coke residue, indicating weak polymer matrix stabilization.
Thermal analysis of ABS-based composites modified with o-, m-, and p-CPhMI shows clear differences in thermal stability and glass-transition behavior.
The o-CPhMI/ABS composite demonstrated the highest thermal stability, with the main decomposition starting at approximately 325–330 °C, the DTG peak occurring at around 421 °C, and the average glass transition temperature (Tg) being 107 °C. The composite retained its structural rigidity and had a low coke residue (~2%), indicating effective stabilization of the polymer matrix.
The thermal properties of the p-CPhMI/ABS composite are also improved compared to pure ABS, exhibiting a Tg of 106 °C and a slightly lower decomposition onset temperature (~312 °C), with a carbon residue of (~4.5%).
The m-CphMI/ABS composite demonstrated the lowest thermal stability: Tg 80 °C, thermal decomposition range ~317–423 °C, and minimum residue (~1.2%).
3. Materials and Method
3.1. Chemicals
In order to obtain antibacterial ABS compositions characterized by a broad spectrum of biological activity, 0.5% (by weight) of CPhMI isomers were introduced into the composition of the materials during the processing stage [38]. The composition of the initial ABS compositions included 70 wt% ABS and 30 wt% magnesium hydroxide (Mg(OH)2).
When preparing ABS-based composite materials, four samples with different compositions were formed. Sample CM1 contained 70 wt.% ABS, 30 wt.% magnesium hydroxide (Mg(OH)2) and 0.5 wt.% o-CPhMI. In sample CM2, 0.5% by mass of m-CPhMI was used instead of the o-isomer, and sample CM3 contained 0.5% by mass of p-CPhMI. Control sample CM4 consisted of 70% by mass % ABS and 30 wt.% magnesium hydroxide without CPhMI additives. All ingredients were thoroughly mixed, then extruded at a temperature of 170–200 °C and pressed into standard plates under a pressure of 10–14 MPa.
3.2. Instruments
The prepared composite materials were characterized by using a variety of techniques. The IR spectra of the samples were recorded on an Agilent Cary 630 FTIR spectrometer (Agilent Technologies, Santa Clara, CA, USA) using a ZnSe crystal in the wavenumber range of 600–4000 cm−1. UV spectra were obtained in the range of 200–800 nm using an identical instrument setup.
The resulting mixtures were extruded using a WPM apparatus (VEB Thüringer Industriewerk Rauenstein; IIRT-Plastomer extruder, Rauenstein, Germany) at a temperature range of 170–200 °C. During the extrusion process, the materials were thoroughly homogenized, ensuring uniform dispersion of all additives within the ABS matrix, which is critical for achieving consistent physico-mechanical and thermal properties in the final composite. The density of the resulting composites was measured using an IIRT-M device, specifically designed for determining the density of polymer alloys. This instrument allows for precise and reproducible measurements, providing critical data for assessing the effect of additives on the composite’s structural compactness and overall material performance.
3.3. The Study of Antibacterial Properties of CM Based on o-, m-, p-CPhMI/ABS
The antimicrobial activity of synthesized monomers was evaluated using the disk diffusion method [39]. All microorganisms studied were examined in a vegetative (non-spore-forming) state, and experiments were conducted using actively growing cultures in the logarithmic phase. The microorganisms studied included Staphylococcus aureus (Gram-positive), Escherichia coli and Pseudomonas aeruginosa (Gram-negative), Bacillus anthracoides (gram-positive spore-forming bacterium), Klebsiella pneumoniae (encapsulated Gram-negative bacterium), and Candida albicans (yeast-like fungus).
Microbial suspensions were evenly inoculated onto nutrient agar plates, after which the test samples were applied. Antimicrobial activity was assessed by the formation and diameter of inhibition zones around the samples, reflecting their effect on the vegetative cells of bacteria and fungi.
3.4. Antibacterial Methodology
The disk-diffusion method was used to study the antibacterial and antifungal properties of maleimides. To evaluate antimicrobial activity, a range of microorganisms was used, including Staphylococcus aureus (Gram-positive), Escherichia coli and Pseudomonas aeruginosa (Gram-negative), Bacillus anthracoides (spore-forming Gram-positive), Klebsiella pneumoniae (capsular Gram-negative) and Candida albicans (fungus).
Microbial suspensions were prepared from fresh daily cultures by diluting approximately 1 mL of microbial cells in 1 mL of sterile physiological solution. Each suspension was evenly spread onto Petri dishes containing appropriate growth media—Meat-Peptone Agar (APA) for bacteria and Sabouraud Agar for fungi. Excess suspension was removed with a pipette and safely discarded in disinfectant. The inoculated plates were allowed to dry at 37 °C for 10 min.
Sterile disks, preheated on a sterile surface for 3–5 min, were placed gently onto the inoculated media using sterile forceps, ensuring good contact with the surface. Plates with APA were incubated at 37 °C, while those with Sabouraud medium were incubated at 28 °C. The active compounds diffused into the agar from the disks, inhibiting microbial growth. After 24–48 h of incubation, the plates were examined, and the zones of inhibition were recorded.
Three types of fungi were used in the study: Aspergillus niger, Aspergillus ochraceus, and Fusarium nugamai, grown on a nutrient medium with agar-saburo. The working chamber was pre-disinfected with alcohol, after which a UV-C germicidal lamp (254 nm) was switched on to maintain sterility. The culture medium was melted on a heating surface and poured into Petri dishes under an open flame to minimize contamination. Each dish was filled to approximately one-third of its volume.
After the medium had dried, the fungal mycelium was inoculated using sterile lancets, placing the plastic samples under investigation next to the cultures. Incubation was carried out at 28 °C for 1 month to study the effect of fungi on plastic.
Preparation of the medium: 65.5 g of agar-saburo was dissolved in 1 L of distilled water and autoclaved for 15 min at 1 atm. After autoclaving the medium was cooled to a temperature suitable for filling and filtration.
3.5. In Silico Studies
In silico studies were conducted using such software as PASS online v2.0 [https://www.way2drug.com, accessed on 18 November 2025], ProTox 3.0 [https://tox.charite.de/protox3, accessed on 18 November 2025] and CarcinoPred-EL (http://112.126.70.33/toxicity/CarcinoPred-EL/result/?id=W9nk0Y4K3oTGql8OoXzc, accessed on 18 November 2025). These analyses were performed to support the experimental investigation using established online prediction platforms. The antimicrobial potential of the initial low-molecular-weight compound was evaluated using the PASS Online (Way2Drug) server, which predicts biological activity based on structure–activity relationship (SAR) models. Predictions were generated for all positional isomers using default parameters. The potential carcinogenicity of monomers was assessed using the CarcinoPred-EL web server. This platform employs ensemble machine-learning approaches, including Random Forest (RF), Support Vector Machine (SVM), and XGBoost algorithms, in combination with multiple molecular descriptors, such as CDK, CDKExt, CDKGraph, KR, KRC, MACCS, and PubChem fingerprints. All calculations were carried out using the standard settings provided by the server. The in silico results were used for preliminary evaluation and comparative analysis and were intended to complement, but not replace, experimental biological and toxicological studies.
3.6. Study of Viscosity of the Composition
The viscosity of the samples under investigation was determined using an Anton Paar rotational viscometer, which operates based on measuring the torque required to rotate a spindle immersed in the liquid sample. Additionally, a Stabinger Viscometer SVM 3000 (Anton Paar GmbH, Graz, Austria) was used, which determines viscosity and density simultaneously using a combined rotational and oscillating U-tube measurement principle. The resistance to rotation is proportional to the viscosity, which makes it possible to accurately determine the rheological characteristics of the material at different shear rates and temperatures.
The dynamic and kinematic viscosities of composite materials based on o-, m-, and p-CPhMI/ABS were measured using an Anton Paar rotational viscometer (MCR series), following a methodology analogous to that reported in [33,34]. Samples were equilibrated at the target temperatures (15, 25, 35, and 45 °C) for at least 10 min prior to measurement and gently stirred to remove air bubbles. Dynamic viscosity was measured in rotational mode using a cone-and-plate spindle suitable for low-viscosity polymer composites, with shear rates varied according to the manufacturer’s recommendations to confirm Newtonian behavior. Kinematic viscosity was calculated from the dynamic viscosity and sample density (ν = η/ρ), with densities determined using a pycnometer at the corresponding temperatures. All measurements were performed in triplicate, and the mean values were reported; variability between repeats was within ±2%. The viscometer was calibrated prior to each measurement series according to standard procedures. The temperature-dependent viscosity data were analyzed to assess the effect of isomeric structure (o-, m-, p-) of the CPhMI fragment on macromolecular mobility and intermolecular interactions.
3.7. Thermal Analysis of the Composition (DTA/TGA)
Thermal analysis of the composites was carried out using a Netzsch STA 449 F3 instrument in the temperature range of 20–1650 °C at heating rates from 0.001 to 50 °C/min. The system provides a temperature control accuracy of ±0.3 °C, allows a maximum sample mass of up to 5 g, and offers a resolution of 1 µg. Measurements were conducted under controlled gas atmospheres (N2, Ar, O2, H2, or air) with flow rates between 5 and 250 mL/min. The thermal stability of the composites was evaluated using characteristic parameters T0, T50, and Tmax.
4. Conclusions
In this study, ABS-based composite materials modified with o-, m-, and p-carboxyphenylmaleimides were successfully prepared by thermal mixing. Spectroscopic analyses confirmed the formation of strong intermolecular interactions between ABS and the modifiers, while UV spectra revealed characteristic absorption bands typical of conjugated aromatic imide systems. Thermal analysis showed that the in-corporation of carboxyphenylmaleimides improves the thermal stability of ABS, with the o-isomer providing the highest glass transition temperature and thermal resistance. Rheological measurements indicated a decrease in viscosity with increasing temperature for all composites, with the m-isomer exhibiting the highest melt fluidity. All modified materials demonstrated pronounced antibacterial activity against Staphylococcus aureus and Escherichia coli, as well as antifungal activity against Candida albicans. These findings highlight the potential of the developed composites for applications in medical devices, hygienic coatings, and antimicrobial packaging.
Author Contributions
Conceptualization, E.G. and B.M.; methodology, S.G. and A.A.; software, E.G.; validation, E.G. and S.G.; formal analysis, S.G. and A.A.; investigation, S.G.; resources, K.H.; data curation, K.H. and A.A.; writing—original draft preparation, S.G. and A.A.; writing—review and editing, E.G. and B.M.; visualization, E.G. and S.G.; supervision, E.G.; project administration, S.G. All authors have read and agreed to the published version of the manuscript.
Funding
This research received no external funding.
Institutional Review Board Statement
Not applicable.
Informed Consent Statement
Not applicable.
Data Availability Statement
The original contributions presented in this study are included in the article. Further inquiries can be directed to the corresponding author(s).
Conflicts of Interest
The authors declare no conflicts of interest.
Abbreviations
The following abbreviations are used in this manuscript:
| ABS | acrylonitrile–butadiene–styrene |
| BAAs | biologically active additives |
| CM | composite materials |
| CPhMI | carboxyphenylmaleimide |
| DTA | differential thermal analysis |
| TGA | thermogravimetric analysis |
| IR | Infrared Spectroscopy |
| UV | ultraviolet spectroscopy |
| S. aureus | Staphylococcus aureus |
| P. aeruginosa | Pseudomonas aeruginosa |
| E. coli | Escherichia coli |
| C. albicans | Candida albicans |
References
- Patravale, V.; Disouza, J.I.; Shahiwala, A. Polymers for Pharmaceutical and Biomedical Applications: Fundamentals, Selection, and Preparation; Elsevier: Amsterdam, The Netherlands, 2024; pp. 14–180. [Google Scholar]
- Haktaniyan, M.; Bradley, M. Polymers showing intrinsic antimicrobial activity. Chem. Soc. Rev. 2022, 51, 8584–8605. [Google Scholar] [CrossRef]
- Andre, V.; Thomas, R.; Martin, Z. Use of Polymeric or Oligomeric Active Ingredients for Medical Devices. Pat. RF 2 557 937C2, 27 July 2015. [Google Scholar]
- Pisoschi, A.M.; Pop, A.; Georgescu, C.; Turcuş, V.; Olah, N.K.; Mathe, E. An overview of natural antimicrobials role in food. Eur. J. Med. Chem. 2018, 143, 922–935. [Google Scholar] [CrossRef]
- Dontsova, E.P.; Zharnenkova, O.A.; Snezhko, A.G.; Uzdensky, V.B. Polymer materials with antimicrobial properties. Plastic 2014, 131, 30–35. [Google Scholar]
- Kovylin, R.S.; Aleynik, D.Y.; Fedushkin, I.L. Modern porous polymer implants: Synthesis, properties, and application. Polym. Sci. Ser. C 2021, 63, 29–46. [Google Scholar] [CrossRef]
- Olmos, D.; González-Benito, J. Polymeric Materials with Antibacterial Activity: A Review. Polymers 2021, 13, 613. [Google Scholar] [CrossRef]
- Zeng, W.; He, J.; Liu, F. Preparation and properties of antibacterial ABS plastics based on polymeric quaternary phosphonium salts antibacterial agents. Polym. Adv. Technol. 2019, 30, 2515–2522. [Google Scholar] [CrossRef]
- Rasulzade, N.S.; Alikhanova, A.I.; Bakhshaliyeva, K.F.; Muradov, P.Z. Method for Obtaining Antibacterial Polymer Composite Material. Pat İ 2023 0057, 23 June 2023. [Google Scholar]
- Yudin, V.V.; Kulikova, T.I.; Morozov, A.G.; Egorikhina, M.N.; Rubtsova, Y.P.; Charykova, I.N.; Linkova, D.D.; Zaslavskaya, M.I.; Farafontova, E.A.; Kovylin, R.S.; et al. Features of Changes in the Structure and Properties of a Porous Polymer Material with Antibacterial Activity during Biodegradation in an In Vitro Model. Polymers 2024, 16, 379. [Google Scholar] [CrossRef]
- Trifonova, O.M.; Panova, Y.A.; Akhmetov, I.G. Study of the effect of maleic anhydride on the synthesis, morphology, and properties of ABS plastic. Plast. Masses 2017, 45, 13–17. [Google Scholar]
- Zhao, Q.; Zhan, Y.; Liu, F.; He, M. Synthesis of Functionalized Poly(N-(3-carboxyphenyl)maleimide-alt-styrene) and Its Heat-Resistance Mechanism. Polym. Sci. Ser. B 2020, 62, 368–374. [Google Scholar] [CrossRef]
- Anjos, E.G.R.; Marini, J.; Montagna, L.S.; Thaís Montanheiro, L.A.; Passador, F.R. Reactive processing of maleic anhydride-grafted ABS and its compatibilizing effect on PC/ABS blendsn. Polímeros 2020, 30, e2020039. [Google Scholar] [CrossRef]
- Tambrallimath, V.; Keshavamurthy, R.; Saravanabavan, D.; Koppad, P.G.; Kumar, G.S.P. Thermal behavior of PC-ABS based graphene filled polymer nanocomposite synthesized by FDM process. Compos. Commun. 2019, 15, 129–134. [Google Scholar] [CrossRef]
- Bakır, A.A.; Atik, R.; Özerinç, S. Mechanical properties of thermoplastic parts produced by fused deposition modeling: A review. Rapid Prototyp. J. 2021, 27, 537–561. [Google Scholar] [CrossRef]
- Nguyen, T.; Thomas, D. Development of non-toxic antimicrobial additives for polymer surfaces. Polym. Adv. Technol. 2019, 30, 1321–1334. [Google Scholar]
- Khan, M.A.U.; Sailaja, R.R.N. Mechanical and Flammability Characteristics of PC/ABS Composites Loaded with Flyash Cenospheres and Multiwalled Carbon Nanotubes. Polym. Compos. 2017, 38, 1043–1052. [Google Scholar]
- Dal Lago, E.; Cagnin, E.; Boaretti, C.; Roso, M.; Lorenzetti, A.; Modesti, M. Influence of Different Carbon-Based Fillers on Electrical and Mechanical Properties of a PC/ABS Blend. Polymers 2020, 12, 29. [Google Scholar] [CrossRef] [PubMed]
- Asyadi, F.; Jawaid, M.; Hassan, A.; Wahit, M.U. Mechanical Properties of Mica-Filled Polycarbonate/Poly(Acrylonitrile-Butadiene-Styrene) Composites. Polym.-Plast. Technol. Eng. 2013, 52, 727–736. [Google Scholar] [CrossRef]
- Zhang, A.; Zhao, G.; Hui, Y.; Guan, Y. Mechanical and thermal properties of ABS/PMMA/Potassium Titanate Whisker Composites. Polym.-Plast. Technol. Eng. 2017, 56, 382–390. [Google Scholar] [CrossRef]
- Shao, C.; Shang, P.; Mao, Y.; Li, Q.; Wu, C. Preparation and characterization of ABS/anhydrous cobalt chloride composites. Mater. Res. Express. 2018, 5, 015309–015324. [Google Scholar] [CrossRef]
- Okolie, O.; Kumar, A.; Edwards, C.; Lawton, L.A.; Oke, A.; McDonald, S.; Thakur, V.K.; Njuguna, J. Bio-based sustainable polymers and materials: From processing to biodegradation. J. Compos. Sci. 2023, 7, 213. [Google Scholar] [CrossRef]
- Kannan, S.; Ramamoorthy, M. Mechanical characterization and experimental modal analysis of 3D Printed ABS, PC and PC-ABS materials. Mater. Res. Express 2020, 7, 015341. [Google Scholar] [CrossRef]
- Bulanda, K.; Oleksy, M.; Oliwa, R. Polymer Composites Based on Polycarbonate/Acrylonitrile-Butadiene-Styrene Used in Rapid Prototyping Technology. Polymers 2023, 15, 1565. [Google Scholar] [CrossRef] [PubMed]
- Wang, X.; Li, P.; Zhou, Y. Maleimide-modified ABS composites: Thermal stability and structural behavior. Polym. Degrad. Stab. 2020, 176, 109146. [Google Scholar]
- Mohamed, H.G.; Mohamed, A.A.; Waheedullah, G.; Naheed, S.; Mohammad, A.; Mohammad, J.; Othman, Y.A. Flexural thermal and dynamic mechanical properties of date palm fibres reinforced epoxy composites. J. Mater. Res. Technol. 2019, 8, 853–860. [Google Scholar] [CrossRef]
- Bhaskar, R.; Butt, J.; Shirvani, H. Investigating the Properties of ABS-Based Plastic Composites Manufactured by Composite Plastic Manufacturing. J. Manuf. Mater. Process. 2022, 6, 163. [Google Scholar] [CrossRef]
- Guliyeva, S.I.; Mammadov, B.A.; Garaev, E.A.; Alikhanova, A.I.; Rasulov, N.S. Method for Obtaining Antibacterial Composite Materials from Carboxyphenylmaleimide and ABS. Eurasian Patent No. 202591072/09/01, 22 October 2025. [Google Scholar]
- El-Azazy, M. Infrared Spectroscopy—Principles, Advances, and Applications Introductory Chapter: Infrared Spectroscopy—A Synopsis of the Fundamentals and Applications; IntechOpen: London, UK, 2018; Volume 220. [Google Scholar]
- Kaye, H. Encyclopedia of Infrared Spectroscopy: Volume III (Polymers, Biopolymers and Minerals Technology); NY Research Press: New York, NY, USA, 2015; Volume 334. [Google Scholar]
- El-Azazy, M.; Al-Saad, K.; El-Shafie, A.S. Infrared Spectroscopy—Perspectives and Applications; IntechOpen: London, UK, 2023; Volume 220. [Google Scholar]
- Lagunin, A.; Stepanchikova, A.; Filimonov, D.; Poroikov, V. PASS: Prediction of activity spectra for biologically active substances. Bioinformatics 2000, 16, 747–748. [Google Scholar] [CrossRef]
- Dos Anjos, E.G.R.; Braga, N.F.; Ribeiro, B.; Escanio, C.A.; Cardoso, A.d.M.; Marini, J.; Antonelli, E.; Passador, F.R. Influence of blending protocol on the mechanical, rheological, and electromagnetic properties of PC/ABS/ABS-g-MAH blend-based MWCNT nanocomposites. J. Appl. Polym. Sci. 2021, 139, e51946. [Google Scholar] [CrossRef]
- Gupta, R.K. Polymer and Composite Rheology, 2nd ed.; CRC Press: Boca Raton, FL, USA, 2000; Volume 408. [Google Scholar]
- Assad, M.E.H.; Khosravi, A.; Hashemian, M. The Fundamentals of Thermal Analysis; Nova Science Publishers: Hauppauge, NY, USA, 2023; Volume 242. [Google Scholar]
- Wagner, M. Thermal Analysis in Practice, Fundamental Aspects; Carl Hanser Verlag: München, Germany, 2018; Volume 349. [Google Scholar]
- Sitnikova, V.E.; Ponomareva, A.A.; Uspenskaya, M.V. Methods of Thermal Analysis: Practical; ITMO University: Saint-Petersburg, Russia, 2021; Volume 151. [Google Scholar]
- Guliyeva, S.I.; Alikhanova, A.I.; Garayev, E.A.; Mammadov, B.A.; Rasulov, N.S. Synthesis of carboxyphenymaleimides and study of their biological activity properties. Am. Sci. J. 2021, 52, 24–29. [Google Scholar]
- Murray, P.R.; Rosenthal, K.S.; Pfaller, M.A. Medical Microbiology, 10th ed.; Elsevier: Amsterdam, The Netherlands, 2025; Volume 953. [Google Scholar]
Disclaimer/Publisher’s Note: The statements, opinions and data contained in all publications are solely those of the individual author(s) and contributor(s) and not of MDPI and/or the editor(s). MDPI and/or the editor(s) disclaim responsibility for any injury to people or property resulting from any ideas, methods, instructions or products referred to in the content. |
© 2026 by the authors. Licensee MDPI, Basel, Switzerland. This article is an open access article distributed under the terms and conditions of the Creative Commons Attribution (CC BY) license.